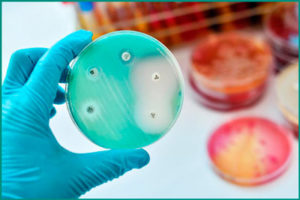
image

Содержание
Заболевания, передающиеся половым путем, являются проблемой, которая встречается одинаково часто у мужчин и женщин. Одним из таких заболеваний является гонорейный уретрит, вызываемый специфическим возбудителем – Neisseria gonorrhoeae, который был открыт в 1879 году. Источником распространения этой инфекции является зараженный человек. Особенность этих инфекций заключается в том, что они не вызывают иммунитета. В системе МКБ 10 гонококковая инфекция нижних отделов мочеполового тракта имеет код А54.
Специфика заболевания «Гонорейный уретрит»
Уретрит – это воспалительное заболевание, которое возникает на стенках мочеиспускательного канала. В зависимости от возбудителя, можно выделить гонорейный, вирусный или трихомонадный вид уретрита. Особую опасность представляет гонококковый уретрит, так как инфекция может распространяться не только на половые органы, но и на другие внутренние органы. При заражении, микробы попадают на слизистую уретры и начинают активно размножаться, постепенно разрушая здоровые клетки эпителия. В результате развивается гнойный процесс и происходит распад тканей.
Важно отметить, что особенность этого заболевания заключается в том, что бактерии способны проникать в клетки различных тканей и сохранять свою активность в организме на протяжении длительного времени, что приводит к разрушительному воздействию.
Комплекс симптомов у мужчин и женщин
Инфицирование гонококковым уретритом проходит через три фазы. Первая фаза – латентная, когда нет никаких признаков или проявлений, и начало патологического процесса может быть случайным или определенным редкими выделениями. Вторая фаза – острый период, характеризующийся яркой клинической симптоматикой, такой как сильная боль и жжение в уретре, усиливающиеся при мочеиспускании, повышение температуры тела, слабость и обильные гнойные выделения. Третья фаза – подострая, когда патологический процесс переходит в хроническую форму, и симптомы становятся менее выраженными или полностью отсутствуют. У мужчин гонококковый уретрит проявляется острой болью, жжением и резью при мочеиспускании, отеком губ уретры, обильными гнойными выделениями с неприятным запахом, склеиванием и покраснением наружного отверстия уретры, а также помутнением урины. У женщин симптомы могут быть менее заметными и включают острую режущую боль при мочеиспускании, зуд наружных половых органов, выделения зеленовато-серого цвета с неприятным запахом и дискомфорт во время сексуального контакта. Гонококковое инфицирование может затрагивать не только уретральный канал, но также слизистый эпителий влагалища, прямую кишку, шейку матки и бартолиновы железы.
Причины развития
Гонорея передается в основном через сексуальные контакты, хотя иногда возможно заражение в бытовых условиях. Риск заражения существует как у детей, так и у взрослых. Факторы, которые могут повлиять на вероятность развития гонореи, включают:
- несистематические половые связи с незнакомыми партнерами;
- ослабленный иммунитет из-за инфекционных (вирусных) заболеваний или приема лекарств;
- использование чужих предметов личной гигиены, таких как белье, мочалки, мыло и полотенца.
Важно помнить, что инкубационный период гонореи обычно составляет около 5 дней, независимо от пола больного.
Перечень осложнений
При появлении первых признаков патологии, врачи рекомендуют немедленно пройти обследование и начать лечение. Если заболевание обнаружено в острой фазе, оно легко поддается лечению и не оставляет последствий. Однако более сложно справиться с патологическим процессом, перешедшим в хроническую форму, или с повторным заражением. Поскольку вредоносный микроорганизм может поражать любые органы, могут возникнуть серьезные осложнения. У мужчин есть несколько возможных осложнений:
- Везикулит – воспаление семенных пузырьков.
- Куперит – появление стойкого болевого синдрома в области бульбоуретральных желез. Повышение температуры и затрудненное мочеиспускание могут указывать на наличие гнойного абсцесса.
- Колликулит – заболевание, поражающее семенной бугорок и вызывающее проблемы с эякуляцией. Возможно появление кровоточивости в этой области.
- Парауретрит – воспаление путей, сопровождающееся покраснением, отеком и незначительными выделениями в утренние часы.
- Простатит – воспаление предстательной железы, сопровождающееся повышением температуры тела, частыми позывами к мочеиспусканию и болью в паху и мошонке.
Однако самым серьезным осложнением считается периуретрит – поражение периуретральной клетчатки и кавернозных тел мочеиспускательного канала. Процесс протекает тяжело и может привести к образованию гнойного абсцесса, стриктуре и искривлению полового члена, вызывающим боли во время эрекции.
У женщин отсутствие адекватного лечения может вызвать воспаление мочевого пузыря, яичников, маточных труб, цервицит и привести к развитию внематочной беременности, выкидышам или бесплодию.
Диагностирование гонорейного типа уретрита
Экспресс-тесты, доступные в аптеках, напоминающие полоски для определения беременности, могут помочь вам избавиться от подозрений о заражении. Если результат положительный, контрольный участок окрасится в розовый цвет.
В медицинских учреждениях специалисты проводят несколько методов диагностики гонококкового уретрита, но предпочтение отдается лабораторным анализам. При ярко выраженных симптомах выполняются следующие исследования:
- Микроскопия окрашенного мазка.
- Культивирование бактерии на питательной среде.
- РИФ. Исследование образца после нанесения на него флуоресцентного красителя.
- ИФА. Иммуноферментный анализ для выявления специфических антител.
- ПЦР. Метод цепной реакции полимеразы для обнаружения живых или мертвых микробов.
При хроническом течении болезни проводится высокоинформативное исследование, называемое реакцией Борде-Жангу. Остальные методы в таких случаях часто дают ложные результаты.
Для назначения правильного лечения врач должен различить гонококковый уретрит от других инфекций, передающихся половым путем:
- хламидиоза;
- трихомониаза;
- хронической формы простатита;
- уретрита, вызванного другим инфекционным возбудителем.
Все эти патологии имеют негонококковую этиологию, схожую симптоматику и клиническое течение.
Особенности лечения
После подтверждения диагноза врач назначает соответствующую терапию для лечения гонококкового уретрита. Целью лечения является уничтожение возбудителя, снятие симптомов и лечение воспалительного процесса. Основным методом является применение лекарственных препаратов.
Медикаментозный подход включает использование различных групп препаратов для лечения гонококкового уретрита. После получения результатов после посева мазка назначаются антибактериальные средства, такие как "Левофлоксацин", "Офлоксацин", "Азитромицин", "Цефиксим", "Ципрофлоксацин" и "Цефтриаксон". Все эти препараты обладают широким спектром действия и считаются эффективными против гонококков. "Цефтриаксон" чаще всего применяется, так как он безопасен даже во время беременности. Для лечения зараженных детей рекомендуется препарат "Медоциприн".
Также назначаются иммуностимуляторы, такие как "Метилурацил", "Глицирам" и "Калия оротат", для укрепления иммунитета организма и борьбы с воспалительным процессом. Ферментные препараты, такие как "Алоэ экстракт", "Трипсин" и "Плазмол", направлены на регенерацию поврежденных тканей и восстановление слизистой оболочки.
В комплексной терапии также широко используются средства народной медицины. Хотя они не могут бороться с инфекцией, они могут помочь укрепить организм и повысить иммунитет. Такие средства, как свежая клюква, зеленый чай, экстракт "Кошачий коготь" и толокнянка обыкновенная, зарекомендовали себя хорошо. Также рекомендуется использовать растения, такие как медвежьи ушки, зверобой, хвощ полевой, цветы бессмертника и пижмы, плоды кориандра, шишки хмеля, корень аира или стальника, алтей, крапива двудомная и тысячелистник.
Перед началом применения лекарственных средств рекомендуется проконсультироваться с лечащим врачом.
Профилактика гонококкового уретрита
Гонококковая инфекция имеет свои особенности, которые нужно учитывать при выборе мер профилактики. Возбудитель может сохранять свою жизнеспособность в течение 30 минут до пяти часов, что является временем, необходимым для полного высыхания секрета, содержащего патоген. Риск заражения у детей и родственников больного значительно возрастает при использовании общих полотенец и других предметов личной гигиены. Гонококк погибает при воздействии антисептических растворов, температуры свыше 60°С, прямых солнечных лучей, горячего пара или утюга.
Следует помнить об этом и обрабатывать личные вещи согласно данным рекомендациям. Также важно помнить, что основной способ передачи инфекции – незащищенный половой контакт, поэтому необходимо принимать следующие меры: иметь половые отношения с одним проверенным партнером, избегать случайных связей с незнакомыми людьми и использовать средства индивидуальной защиты, такие как презервативы.
Необходимо соблюдать простые правила гигиены, включающие ежедневные процедуры с использованием антибактериальных или антисептических средств. Рекомендуется также посещать уролога или гинеколога не реже одного раза в год для обследования, даже при отсутствии видимых симптомов.
Совет! После незащищенного сексуального контакта с носителем инфекции рекомендуется обработать половые органы антисептическими средствами, такими как "Хлоргексидин" или "Мирамистин". Это можно сделать самостоятельно или обратившись в венерологический диспансер.
Заключение
Лечение уретрита, вызванного гонореей, является долгим и сложным процессом. Поэтому важно обратиться к специалистам при первых признаках инфицирования. Раннее обнаружение заболевания обеспечивает эффективное лечение и положительный исход.